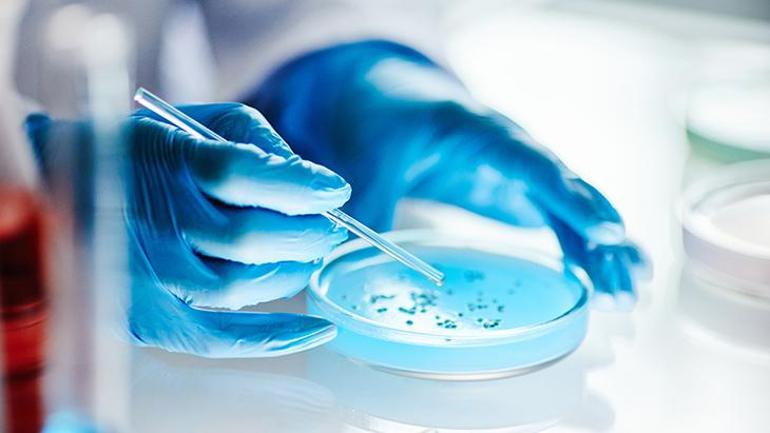

Betül Yasemin Kökbek / Milliyet.com.tr – Bilim insanları, bağırsakta, ağızda ve ciltte yaşayan trilyonlarca mikroorganizmanın oluşturduğu mikrobiyata ekosisteminin, insan sağlığının görünmeyen mimarı olduğunu söylüyor. Özellikle otizm spektrum bozukluğu olan bireylerde mikrobiyota çeşitliliğinin düşüklüğü, yani disbiyozis, hem bağırsak sağlığını hem de günlük yaşamı doğrudan etkileyebiliyor. Faydalı bakterilerin azalması, kısa zincirli yağ asidi üretiminin düşmesi, bağırsak geçirgenliğinin artması, kronik kabızlık, uyku problemleri ve tatlıya aşırı düşkünlük gibi sorunlara yol açabiliyor. Uzmanlar, doğru beslenme, şeker kontrolü ve probiyotik desteği ile bu mikrobiyal eksikliklerin giderilebileceğini söylüyor. Böylece çocuklar, otizmleri değişmese de, kendi potansiyellerini daha net ortaya koyabiliyor. Mikroskobik dünyada başlayan bu denge, günlük yaşamda gözle görülür değişimlere kapı aralıyor. Bilim insanı Ali Rıza Akın Milliyet.com.tr’ye anlattı.
İNSANIN GÖRÜNMEYEN ORGANI: MİKROBİYATA!
‘İnsanın görünmeyen organı’ olarak tanımlanan mikrobiyata bağırsakta, ağızda ve ciltte yaşayan trilyonlarca mikroorganizmanın oluşturduğu canlı bir ekosistem olarak bilinir. “Bu sistem olmadan bağışıklık gelişmez, bağırsak bariyeri korunmaz, metabolizma dengede kalmaz ve en önemlisi beyin tek başına çalışmaz. Serotoninin büyük kısmı bağırsakta üretilir. Bağışıklık sistemi bağırsakta eğitilir. Enflamasyon büyük ölçüde bağırsaktan yönetilir. Mikrobiyota bozulursa, sistem bozulur. Sistem bozulursa, davranış, metabolizma ve nörolojik denge etkilenir” diyerek açıklamalarına başlayan Akın, insanı anlamak için mikrobiyotayı görmezden gelmenin mümkün olmadığının bilgisini verdi.
Sağlıklı bir bireyin mikrobiyata sistemine kıyasla otizm spektrum bozukluğu olan bireylerin önemli bir kısmında mikrobiyota çeşitliliğinin düşük olduğunu söyleyen Akın, disbiyozis olarak adlandırılan bu durumda faydalı bakterilerin azaldığını, kısa zincirli yağ asidi üretiminin düştüğünü, bağırsak geçirgenliğinin artığını ve enflamasyonun yükseldiğinin altını çizdi. Bu tablonun günlük yaşamda da kendini kronik kabızlık, gaz ve şişkinlik, karın ağrısı, uyku problemleri, besin seçiciliği ve tatlılara ya da karbonhidratlara aşırı düşkünlük şeklinde gösterebileceğinin altını çizen Akın, “Ancak bu sadece alışkanlık değildir; bazı bakteri ve mantarlar özellikle Candida şekeri beslenme kaynağı olarak kullanır. Disbiyozis derinleştikçe karbonhidrat isteği artabilir. Bazen çocuk şekeri istemez, aslında mikrobiyal dengesizlik şekeri talep eder“ açıklamasında bulundu.

EKSİK BAKTERİLER TESPİT EDİLİRSE BİRÇOK ŞEY DEĞİŞİR
Otizm spektrum bozukluğu olan bireylerin hangi bakterilerinde eksiklik olduğunu anlatarak açıklamalarına devam eden Bilim insanı Ali Rıza Akın bu durumu şu cümlelerle açıkladı:
“Çalışmalar özellikle şu bakterilerde azalma olduğunu gösteriyor: Bifidobacterium türleri, bazı Lactobacillus türleri ve Akkermansia muciniphila. Bu bakteriler bağırsak bariyerini güçlendirir, enflamasyonu azaltır, bağışıklık sistemini dengeler ve kısa zincirli yağ asitleri üretir. Özellikle Akkermansia, bağırsak mukus tabakasının koruyucusudur. Azaldığında bağırsak geçirgenliği artabilir. Bağırsak bariyeri zayıfladığında sistemik enflamasyon yükselebilir ve enflamasyon bağırsakta kalmaz. Burada şöyle düşünelim: Bir araba 4 tekerlekli olarak tasarlanmıştır. 3 tekerlekli bir araba da yük dengeli dağıtıldığında ilerleyebilir. Otizm de böyledir. İyi eğitimle, doğru terapilerle otizmli bireyler hayatlarını sürdürebilirler. Ancak tasarımda 4 tekerlek vardır. Eksik olan biyolojik destek yani azalmış faydalı bakteriler yerine konduğunda sistem daha stabil çalışabilir. Biz otizmi değiştirmiyoruz. Biz eksik olan biyolojik tekerleği tamamlamaya çalışıyoruz.”

Eksik olan bakterilerin desteklenmesi konusuyla ilgili yalnızca probiyotik almanın yeterli olmadığını söyleyen Akın, “Mesele ekosistemi yeniden kurmaktır. Beslenme temeli olarak liften zengin beslenme, dirençli nişasta ve doğal prebiyotikler önemlidir. Faydalı bakteriler beslenmeden kalıcı denge kurulmaz. Şeker ve rafine karbonhidrat kontrolü de kritiktir. Otizmli bireylerde tatlı ve karbonhidrata aşırı düşkünlük sık görülür. Şeker Candida artışını besleyebilir, disbiyozisi derinleştirebilir ve enflamasyonu artırabilir. Bu nedenle şeker kontrolü kritik önemdedir. Ağız mikrobiyotasının desteklenmesi çoğu zaman ihmal edilen ama çok kritik bir noktadır. Ağız bağırsaktan bağımsız değildir; her yutkunmada ağızdaki mikroorganizmalar sindirim sistemine taşınır. Otizmli bireylerde ağız içi Candida yükü yüksek olabilir“ dedi. Ağızda disbiyozis olması halinde bağırsakta denge kurmanın zorlaşacağını ileten uzman isim bu nedenle içeriğinde Akkermansia, Bifidobacterium ve Lactobacillus bulunan, bilimsel olarak tasarlanmış probiyotik çiğneme tabletlerinin destekleyici olabileceği konusunda uyardı.
“Bu süreçte çiğneme formu önemlidir çünkü bakteriler ağız mukozasıyla temas eder ve oral–bağırsak ekseni birlikte desteklenir.” Bilim insanı Ali Rıza Akın

‘BİZ OTİZMİ DEĞİŞTİRMİYORUZ…’
Açıklamalarını mikrobiyota düzenlemesinin otizmi ortadan kaldırmadığını hatırlatarak devam eden Akın, otizmin nörogelişimsel bir durum olduğunu ancak biyolojik yük azaldığında sistemin de rahatlayabileceğini söyleyerek cümleleri şöyle noktaladı:
“Bağırsak dengelendiğinde kabızlık azalır, gaz ve şişkinlik geriler, uyku iyileşir, huzursuzluk azalır ve tatlıya aşırı düşkünlük azalır. Ve klinikte gözlemlediğimiz daha derin değişimler arasında göz temasında artış, daha sosyal olma yönünde adımlar, ismi söylendiğinde daha optimal tepki verme ve terapilere daha açık hale gelme sayılabilir. Ben bunu şöyle ifade ediyorum: Biz otizmi değiştirmiyoruz, biyolojik gürültüyü azaltıyoruz. Gürültü azaldığında çocuk kendi potansiyelini daha net ortaya koyabiliyor ve bazen en büyük değişim, mikroskobik dünyada başlıyor.”



